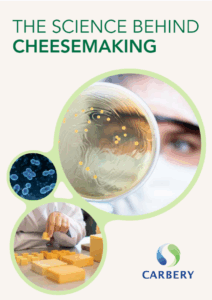

Insight & Innovation
The Art and Science of Cheesemaking
We have a rich tradition of cheesemaking but we marry this heritage with food science and innovation. Our food scientists, cheese makers, microbiologists, cheese graders and chefs are constantly researching and developing new solutions to meet our customers’ requirements and futureproof their product offerings.
For decades we have partnered with leading universities and research institutions to develop and utilise cutting-edge technology and processes that allow us to meet our customers’ unique taste and functionality requirements.
We focus on innovation across four main pillars
- Flavour
- Functionality
- Cultures
- Process
Download the whitepaper The Science Behind Cheesemaking
DownloadContact Us
When you partner with us you have access to our experts in cheese research and development, along with experienced cheese makers and graders, culinary experts and marketing support to help accelerate your product development process and ensure a successful launch.










